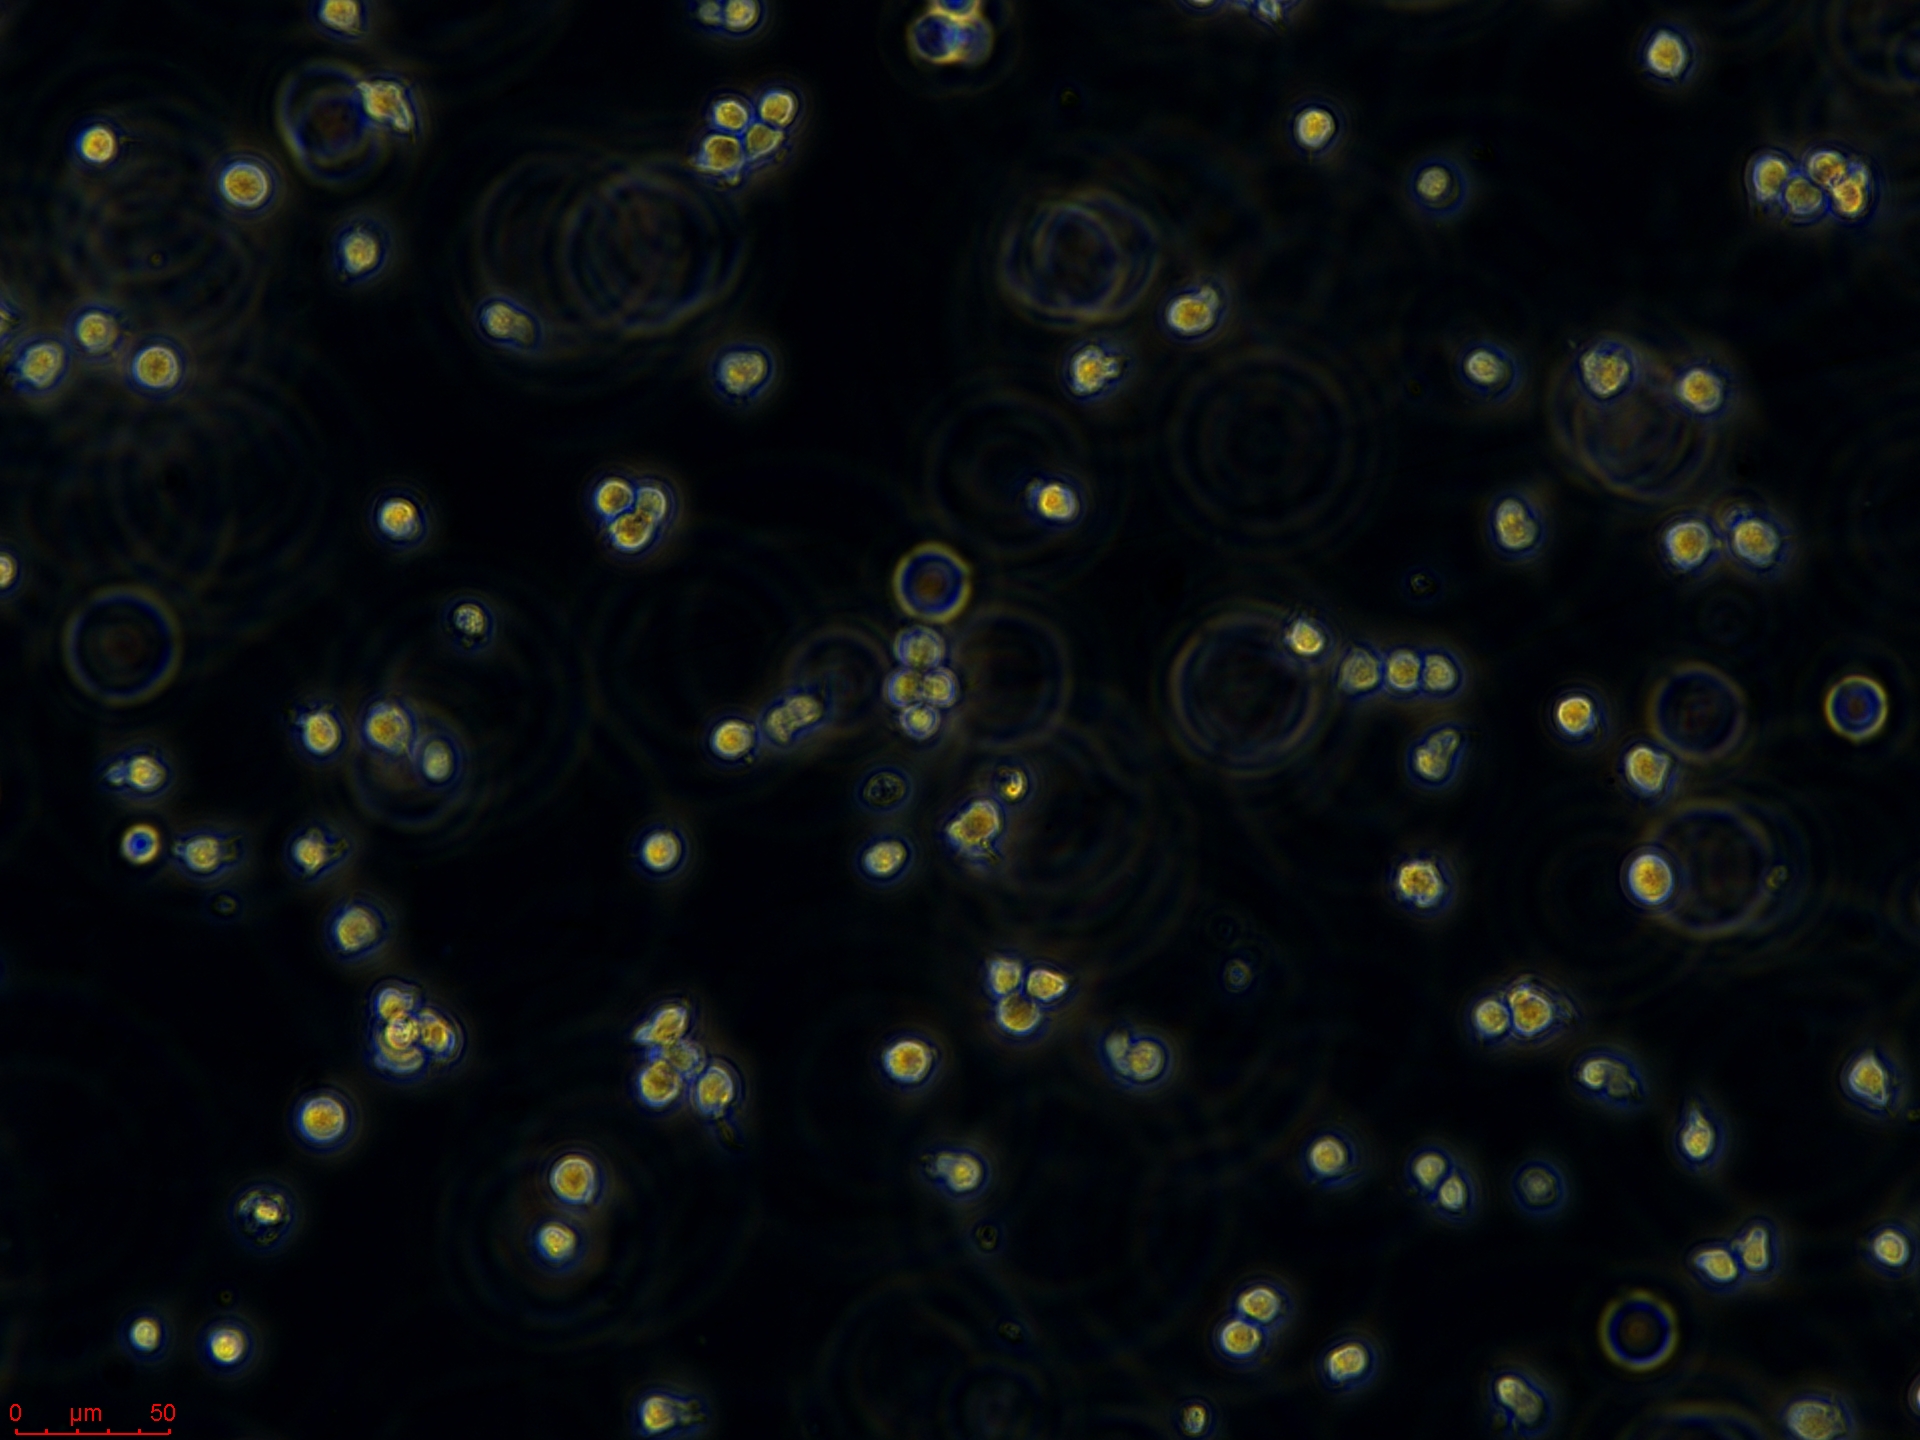
Jurkat 低.jpg
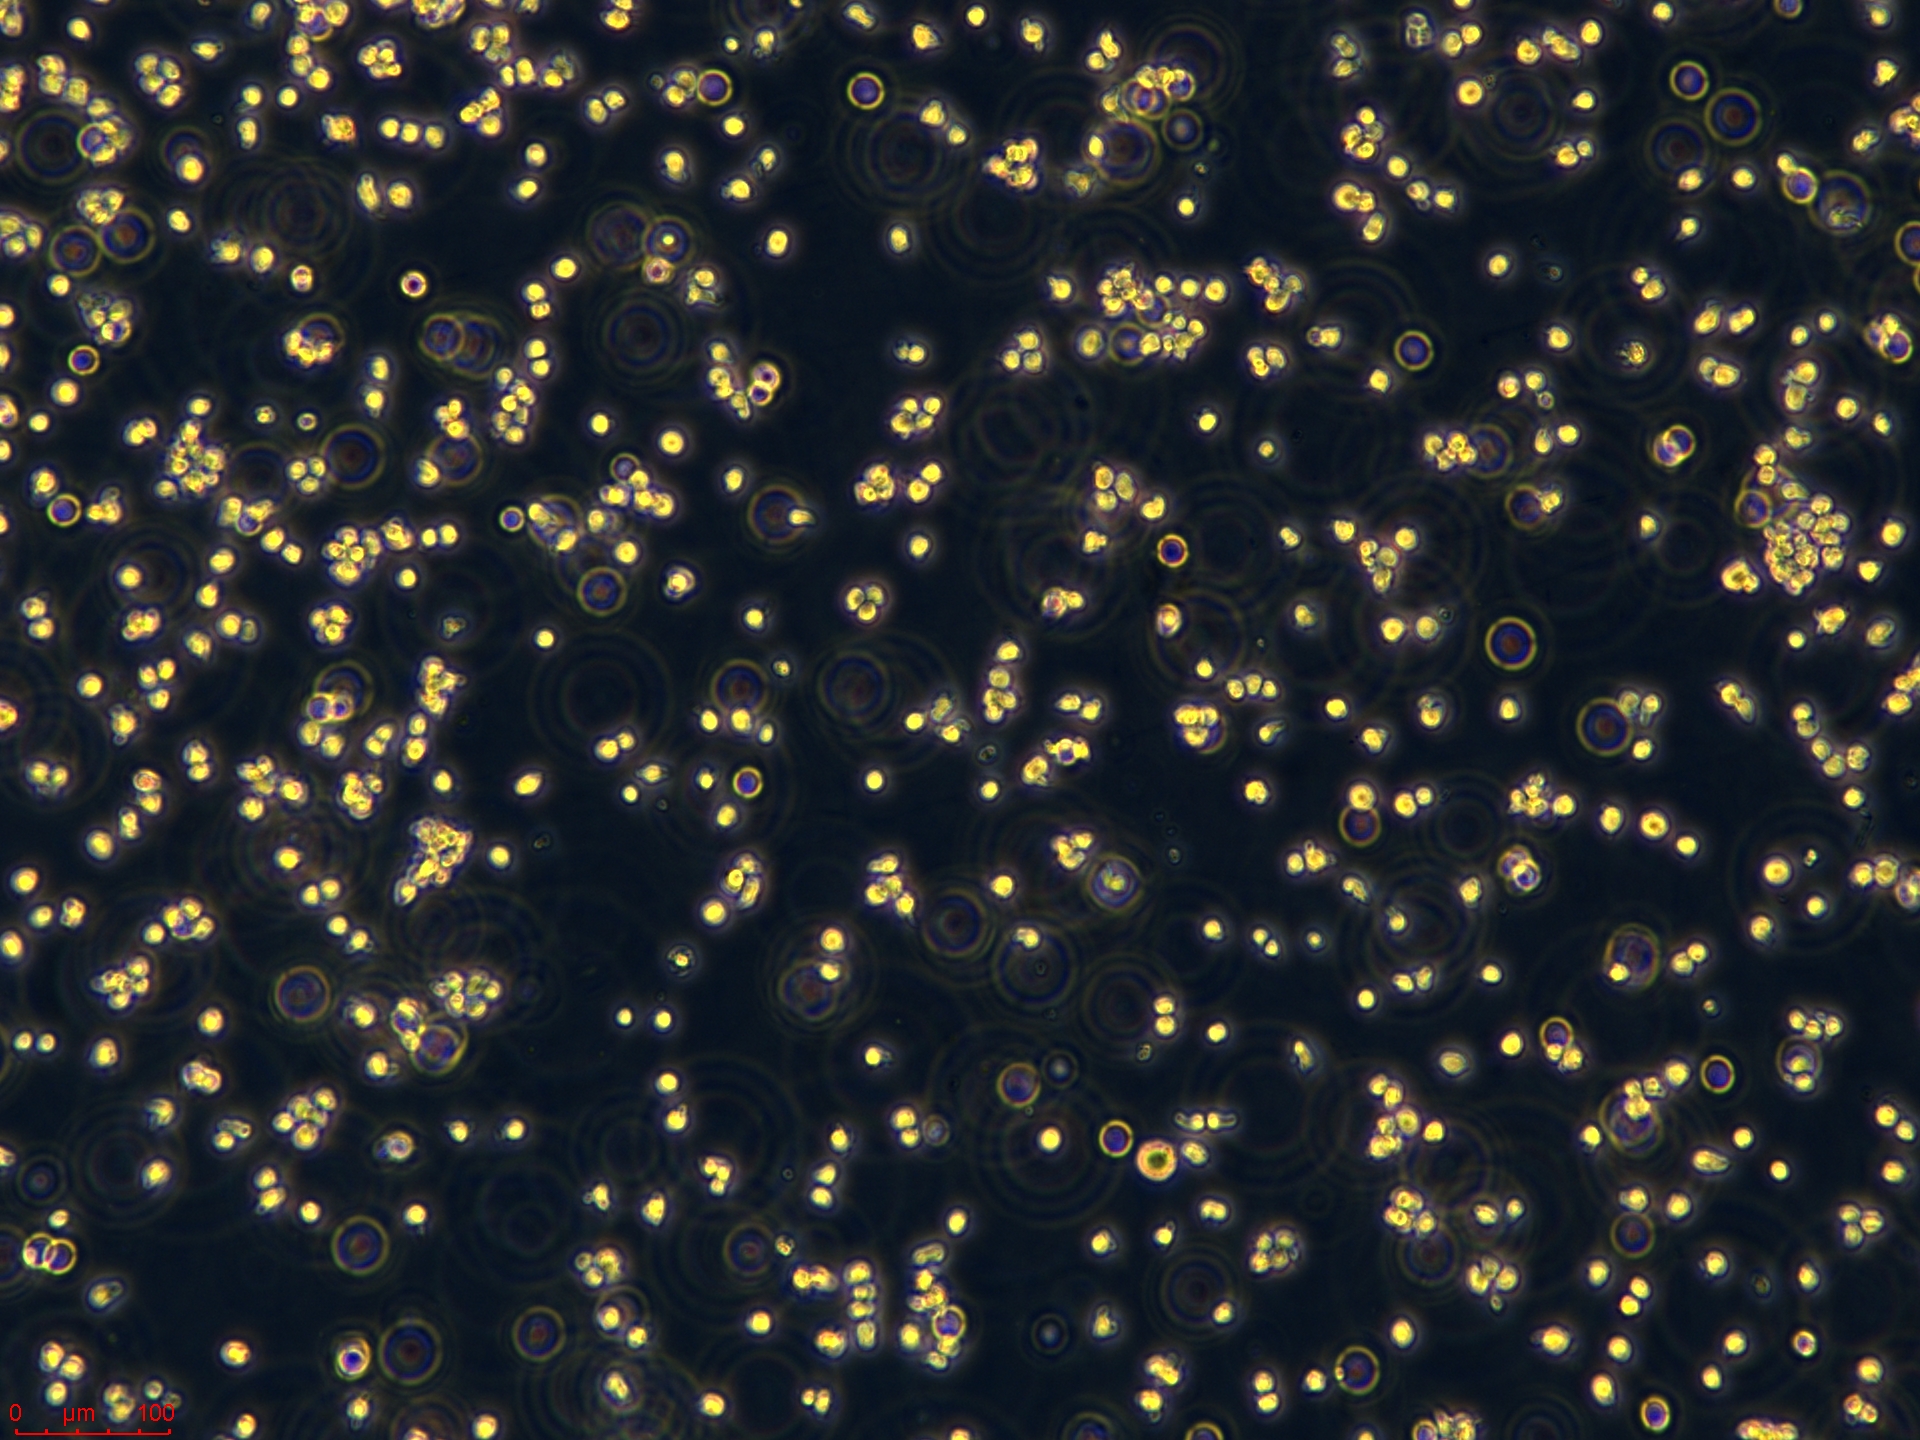
Jurkat 高.jpg
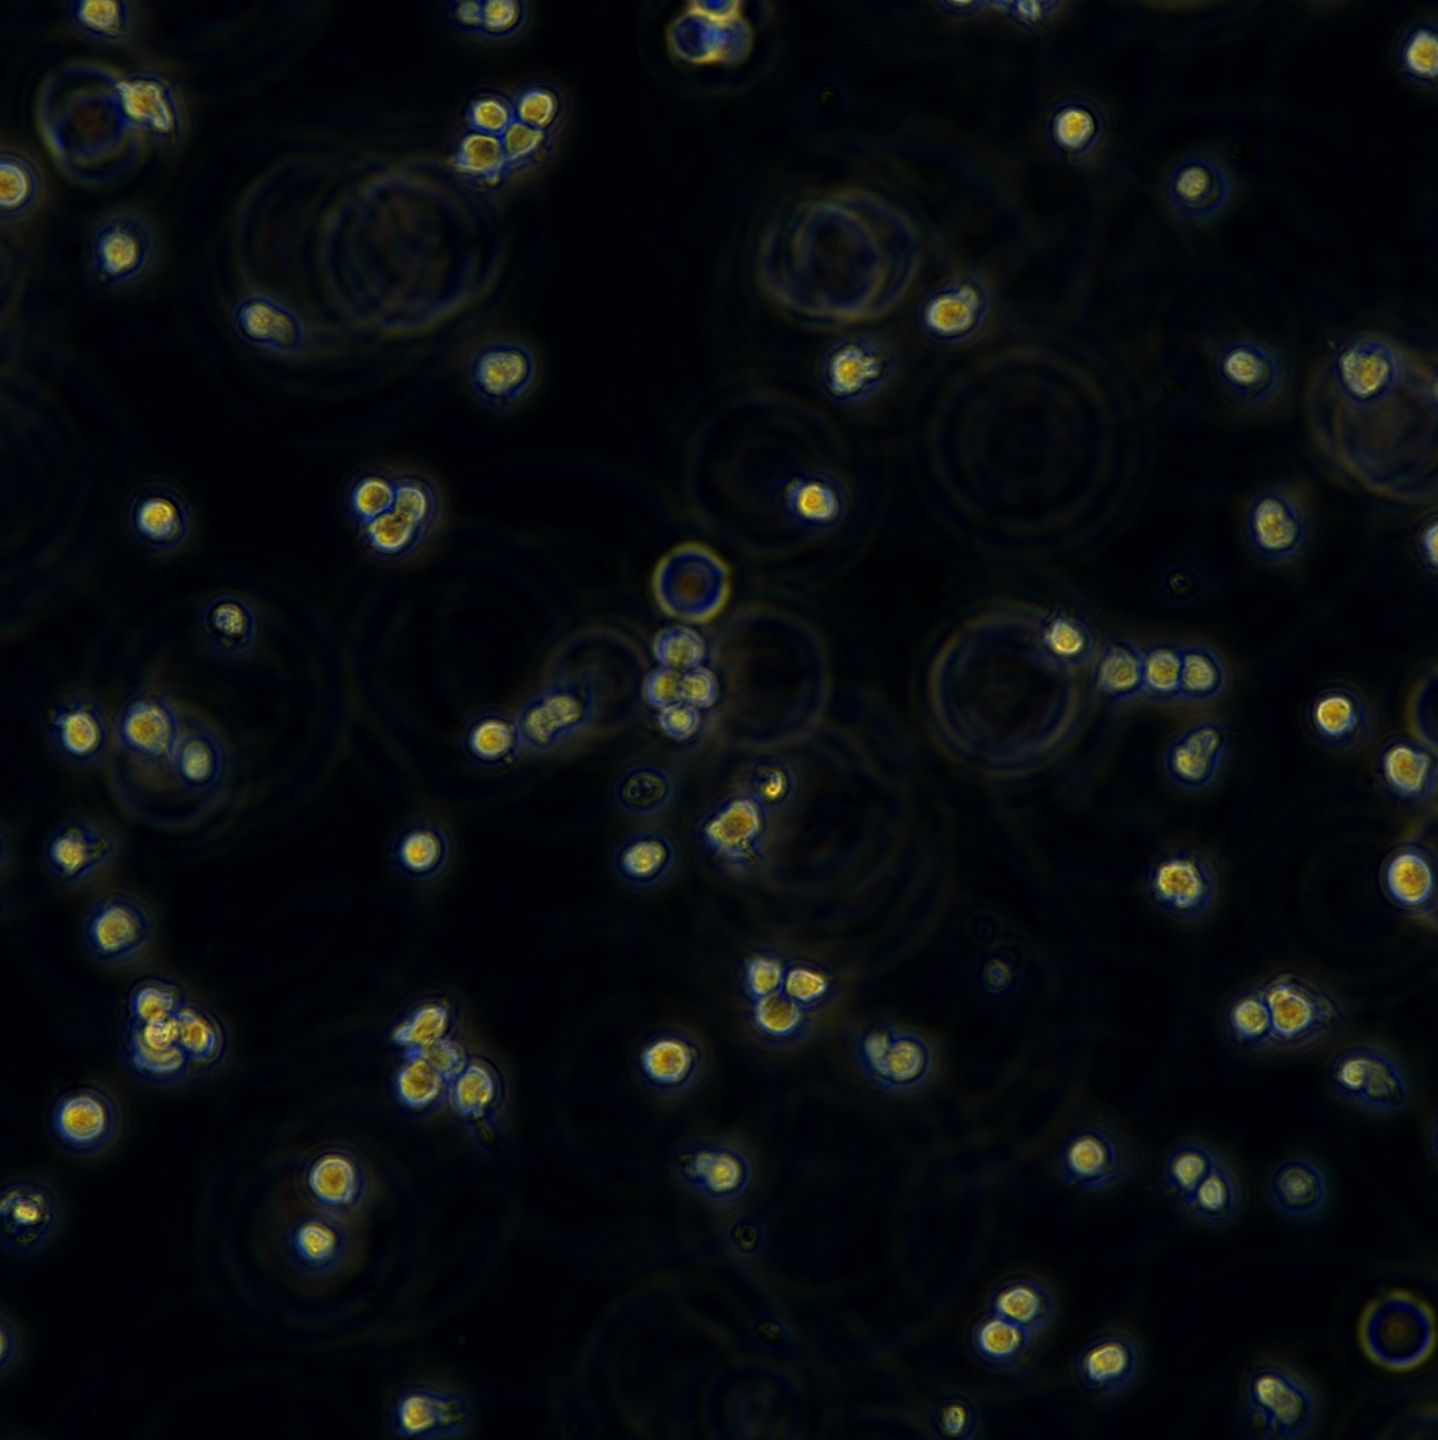
人急性T淋巴细胞白血病细胞Jurkat
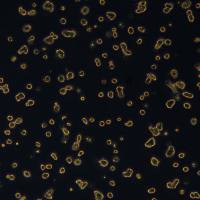
胃癌细胞 SNU719

万千商家帮你免费找货
0 人在求购买到急需产品
- 详细信息
- 询价记录
- 技术资料
- 英文名:
Jurkat
- 库存:
100
- 组织来源:
外周血(Peripheral blood)
- 相关疾病:
急性T细胞白血病(Acute T cell leukemia)
- 物种来源:
人源(Homo sapiens)
- 细胞形态:
淋巴母细胞(Lymphoblast)
- 年限:
14岁(14 Years)
- 生长状态:
悬浮生长(Suspension)
- 规格:
T25/冻存管
| 规格 | T25 |
| 货号 | CTCC-400-0075 |
| 种属 | 人源(Homo sapiens) |
| 组织来源 | 外周血(Peripheral blood) |
| 疾病 | 急性T细胞白血病(Acute T cell leukemia) |
| 年龄 | 14岁(14 Years) |
| 培养体系 | 该细胞系培养所用基本培养基为 RPMI1640 Medium,配置完全培养基时 需加入10%FBS,1% Anti-Anti。 |
| 细胞形态 | 淋巴母细胞(Lymphoblast) |
| 生长特性 | 悬浮生长(Suspension) |

风险提示:丁香通仅作为第三方平台,为商家信息发布提供平台空间。用户咨询产品时请注意保护个人信息及财产安全,合理判断,谨慎选购商品,商家和用户对交易行为负责。对于医疗器械类产品,请先查证核实企业经营资质和医疗器械产品注册证情况。
- 作者
- 内容
- 询问日期
人急性T淋巴细胞白血病细胞Jurkat
¥2600